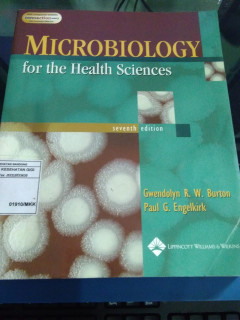
cover

Ditapis dengan

Mikrobiologi kedokteran, Jawetz, Melnick & Adelberg edisi 25
Menghubungkan prinsip dasar dengan diagnosis dan terapi infeksi mikroba, buku teks klasik ini menyampaikan ulasan penting mengenai peran mikroorganisme bagi kesehatan dan penyakit manusia. Di samping penjelasan singkat tentang berbagai organisme, Anda akan menemukan perspektif vital mengenai patogenesis, uji laboratorium diagnostik, temuan klinis, terapi, serta epidemiologi.
- Edisi
- 25
- ISBN/ISSN
- 978-979-044-250-4
- Deskripsi Fisik
- 854 hlm.;illus.;30 cm.
- Judul Seri
- -
- No. Panggil
- 616.01 CAR m RAK 213

MIKROBIOLOGI KEDOKTERAN
Mikrobiologi medis, kadang disebut 'mikrobiologi klinikl mempelajari mikroba-mikroba yang menyebabkan penyakit pada manusia serta peran mereka dalam penyakit itu.
- Edisi
- 20
- ISBN/ISSN
- 979-448-310-9
- Deskripsi Fisik
- xiii,753 HLM; ILUS; 27 CM
- Judul Seri
- MIKROBIOLOGI KEDOKTERAN
- No. Panggil
- 610.01 JAW m

Immunology and Inflammation
A practical text for medical students as well as practitioners in the clinical or basic sciences, combining basic science principles and their clinical relevance as it pertains to disorders of the immune system. The text is divided into three parts; the first describes immunology, the second presents the various components of the inflammatory process, and the third shows how these interact to p…
- Edisi
- -
- ISBN/ISSN
- 0-07-112841-7
- Deskripsi Fisik
- xvi,803 hlm,illus,22 cm
- Judul Seri
- -
- No. Panggil
- 571.96 SIG i

Microbiology For The Health Sciences (MKK). (text book)
Bacteria are among the fastest growing and reproducing microorganisms that can be found anywhere in the world. Humanrnhands exchange microorganisms between the skin surface and the environment, picking up and harboring the colonizationrnof pathogenic species such as bacteria in large quantities along the way. Due to the Covid-19 pandemic, the demand forrnhand sanitizers has sharply increased wo…
- Edisi
- EDISI. 7
- ISBN/ISSN
- 0-7817-4000-2
- Deskripsi Fisik
- 561 hal., ilus
- Judul Seri
- -
- No. Panggil
- 616.01 Lip m

Mikrobiologi Kedokteran=Medical microbiology
Perkembangan mikrobiologi yang mempelajari tentang genetika dan metabolisme mikroba menjadi dasar perkembangan yang pesat dari mikrobiologi kedokteran masa kini. Dalam buku ini dipelajari tentang sifat agen infeksi yaitu, virus, bakteri dan jamur sebagai penyebab penyakit, cara penularannya, mekanisme terjadinya infeksi, aspek klinis dan pengembangbiakan atau kultur mikroorganisme tersebut. Res…
- Edisi
- EDISI 20
- ISBN/ISSN
- 979-448-310-9
- Deskripsi Fisik
- 753 hal., ill
- Judul Seri
- -
- No. Panggil
- 616.01 EGC m

Mikrobiologi terapan untuk perawat
daftar isirn1. mikroorganisme dan penyakitrn2. respos tubuh terhadap infeksirn3. laboratorium mikrobiologirn4. mengobati penyakit infeksirn5. kebijakan pengendalian infeksirn6. mencegah infeksi di rumah sakitrn7. infeksi saluran kemihrn8. infeksi lukarn9. infeksi saluran napasrn10. infeksi yang berkaitan dengan intravaskularrn11. infeksi pencernaanrn12. risiko infeksi dari darah dan cairan tubu…
- Edisi
- -
- ISBN/ISSN
- 979-448-600-0
- Deskripsi Fisik
- xvii, 367 hlm. ; 15,5 x 24 cm
- Judul Seri
- -
- No. Panggil
- 616.01 GOU m
Mikrobiologi untuk Keperawatan
- Edisi
- -
- ISBN/ISSN
- 9795190741
- Deskripsi Fisik
- vi, 105 hlm.; ilus.; 24 cm.
- Judul Seri
- -
- No. Panggil
- 616.01 Jan m
- Edisi
- -
- ISBN/ISSN
- 9795190741
- Deskripsi Fisik
- vi, 105 hlm.; ilus.; 24 cm.
- Judul Seri
- -
- No. Panggil
- 616.01 Jan m
 Karya Umum
Karya Umum  Filsafat
Filsafat  Agama
Agama  Ilmu-ilmu Sosial
Ilmu-ilmu Sosial  Bahasa
Bahasa  Ilmu-ilmu Murni
Ilmu-ilmu Murni  Ilmu-ilmu Terapan
Ilmu-ilmu Terapan  Kesenian, Hiburan, dan Olahraga
Kesenian, Hiburan, dan Olahraga  Kesusastraan
Kesusastraan  Geografi dan Sejarah
Geografi dan Sejarah